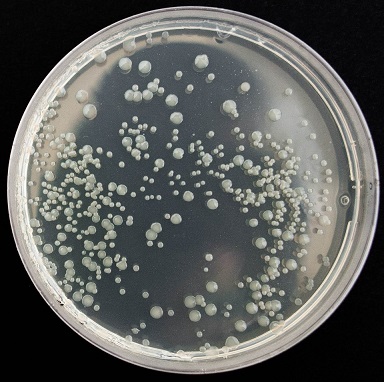

Revised infection prevention and control guidelines for podiatrists
All practising podiatrists and podiatric surgeons must practise within the recommendations of the National Health and Medical Research Council Australian (NHMRC) guidelines as they apply to the practice setting in which they work.
The core principles in the Podiatry Board of Australia’s revised Guidelines for infection prevention and control are to prevent the transmission of infectious organisms and manage infections if they occur. The underpinning key practice principles include:
- An understanding of the modes of transmission of infectious agents and an overview of risk management
- Effective work practices that minimise the risk of selection and transmission of infectious agents
- Governance structures that support the implementation, monitoring and reporting of infection prevention and control work practices, and
- Compliance with legislation, regulations and standards relevant to infection prevention and control.
The guidelines have been developed by the Podiatry Board of Australia to guide podiatrists and podiatric surgeons about appropriate practice as effective infection prevention and control is an integral part of all aspects of their professional practice. The guidelines apply to all registered podiatrists and podiatric surgeons and all individuals that they work with in their practice.
Complete list of the Board’s codes and guidelines can be accessed here.
More articles on My Health Career:
